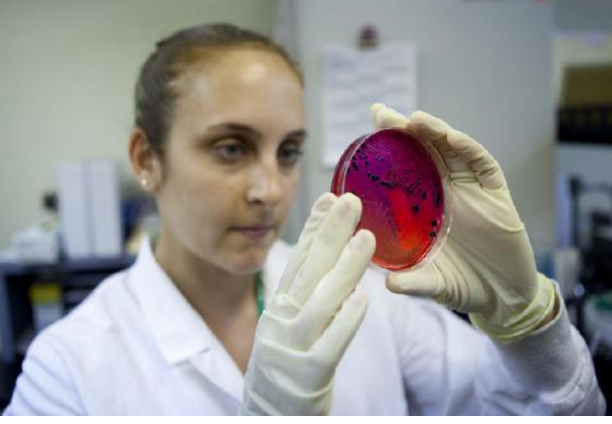

Лечения нет: в США обнаружена неуязвимая "кошмарная бактерия" Читайте больше на https://www.pravda.ru/news/interesting_news/04-04-2018/1379461-usa-0/
Как сообщает USA today со ссылкой на доклад федеральных Центров по контролю и профилактике заболеваний (CDC), в стране нашли более 220 различных разновидностей "кошмарной бактерии".
Первый замдиректора CDC Энн Шукет пояснила, "необходимо предпринять дополнительные усилия, и мы должны действовать быстрее и с опережением".
По ее словам, каждый четвертый образец направленных на анализ бактерий содержал специальные гены, которые позволял микроорганизмам распространять сопротивляемость на другие бактерии. В каждом десятом случае зараженные такими бактериями люди распространяли инфекцию на здоровых людей в госпиталях.
Напомним, в мае 2016 года сообщалось, что органы здравоохранения США выявили в стране первый случай инфекции, не поддающейся лечению ни одним из известных антибиотиков.
"Правда. Ру" ранее сообщала, что исследователи из Эксетерского университета открыли новое побочное действие антибиотиков. Ученые выяснили, что эти препараты ускоряют рост бактерий. Результаты исследований опубликованы в Nature Ecology & Evolution.
Специалисты экспериментировали с кишечной палочкой и антибиотиком доксициклином из группы тетрациклинов, которые тормозят на биосинтез белка в бактериальных клетках.
Кишечная палочка после обработки доксициклином, как и ожидалось, стала устойчивой к антибиотику, но, кроме того, бактерии начинали расти быстрее, и в результате их колонии оказывались в три раза больше, чем колонии бактерий, не отведавших доксициклина. Способность к ускоренному росту сохранялась и после того, как антибиотик убирали из питательной среды.
Читайте больше на Подробнее ➤